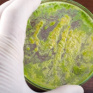
Медики предупредили об угрозе супербактерии, вызывающей бесплодие

Шотландца будут судить за попытки заняться сексом с забором

Житель Шотландии предстал перед судом из-за того, что пытался в общественном месте заняться сексом с деревянным забором и автомобилем такси, пишет The Courier.
По словам свидетелей, 36-летний нетрезвый мужчина на людной улице снял брюки и "начал тереться о забор". Потом он переключился на такси - лег на автомобиль и стал имитировать половой акт.
63-летняя Кэтлин Нисбет на судебном заседании рассказала, что, выглянув в окно, увидела полуобнаженного мужчину, который ходил в спущенных до лодыжек штанах. Потом он, по ее словам, подошел к женщине и начал мастурбировать.
76-летний супруг Нисбет добавил, что возвращался домой и заметил мужчину, справлявшего малую нужду на забор. После этого незнакомец начал тереться об ограждение.
На суде выступил и владелец такси Дон Симпсон, чья машина подверглась сексуальному домогательству шотландца. Симпсон заявил, что отлучился в магазин, а вернувшись, обнаружил мужчину, лежащего на его авто без штанов.
Подсудимый отверг все обвинения. Суд вынесет ему приговор за непристойное поведение в общественном месте 3 февраля.